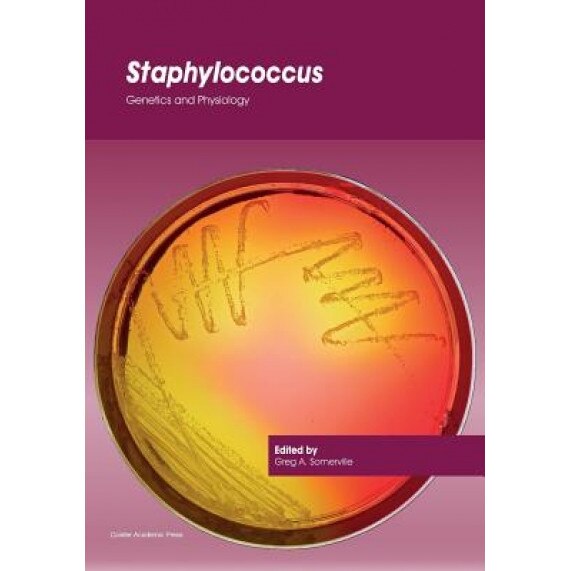
Staphylococcus: Genetics and Physiology, Greg a. Somerville (Editor)

Staphylococcus: Genetics and Physiology, Greg a. Somerville (Editor)

Detalii CAISTER ACADEMIC PR 9781910190494
(0,00/ Recenzii)Categorie: Stiinta si tehnica
Brand: CAISTER ACADEMIC PR
Cod Produs:9781910190494
Compară prețurile
Oferte disponibile pentru CAISTER ACADEMIC PR 9781910190494

Oferte recomandate
Alte oferte
Informație indisponibilă
Transport gratuit
Transport contra-cost
Plata online:
Informație indisponibilă
Acceptă plata online
Fără plata online
Cashback
Informație indisponibilă
Primești Cashback
Fără Cashback
Informație indisponibilă
În stoc
Stoc limitat
Ultimele bucăți
Fără stoc
Indisponibil
Precomandă
În stoc furnizor
La comandă
Ridicare showroom
Istoric de preț
Descriere completă CAISTER ACADEMIC PR 9781910190494
Descriere Staphylococcus: Genetics and - 9781910190494
Produsul Staphylococcus: Genetics and Physiology, Greg a. Somerville (Editor), din categoria Stiinta si tehnica se evidențiază prin selecția urmatoare de specificații care îl fac potrivit pentru nevoile diverse ale consumatorilor: Provine de la brandul CAISTER ACADEMIC PR, format fizic, tip coperta brosata, limba engleza, an publicare 2016, numar pagini 464, gen stiinta, subgen biologie, dimensiune (mm) 177 x 254, greutate 929 g, autor greg somerville, isbn / issn 9781910190494, .
Descoperă cele mai bune oferte în categoria Stiinta si tehnica
Cauți cele mai bune oferte pentru Staphylococcus: Genetics and în categoria Stiinta si tehnica? Ai ajuns în locul potrivit! Pe platforma noastră de comparare prețuri, poți găsi cele mai avantajoase opțiuni de pe piață, economisind bani și timp prețios.
Staphylococcus: Genetics and este un produs popular și apreciat în categoria sa. Compară prețurile de la diferiți comercianți și alege oferta care ți se potrivește cel mai bine nevoilor și bugetului.
De ce să folosești comparatorul nostru de prețuri?
- **Varietate de opțiuni**: Accesezi o gamă largă de oferte și comercianți pentru a găsi produsul dorit.
- **Economisești timp și bani**: Compari prețurile rapid și ușor, pentru a obține cea mai bună ofertă disponibilă.
- **Transparență și obiectivitate**: Informațiile prezentate sunt clare și utile pentru a te ajuta să iei decizia corectă.
Explorează acum cele mai bune oferte pentru Staphylococcus: Genetics and și profită de prețurile competitive din categoria Stiinta si tehnica. Utilizează comparatorul nostru de prețuri pentru a face achiziții inteligente și informate.

3cheaps - compară prețuri pentru Staphylococcus: Genetics and Physiology, Greg a. Somerville (Editor) (9781910190494)
Informațiile despre caracteristicile tehnice, setul de livrare, țara de fabricație și aspectul produselor este doar pentru referință și se bazează pe cele mai recente informații disponibile la momentul publicării.Specificatii 9781910190494
- Format: Fizic
- Tip coperta: Brosata
- Limba: Engleza
- An publicare: 2016
- Numar pagini: 464
- Gen: Stiinta
- Subgen: Biologie
- Dimensiune (mm): 177 x 254
- Greutate: 929 g
- Brand: CAISTER ACADEMIC PR
- Autor: Greg Somerville
- ISBN / ISSN: 9781910190494
Recenzii 9781910190494
(0,00/ Recenzii)Staphylococcus: Genetics and Physiology, Greg a. Somerville (Editor) a obtinut nota 0,00 din media celor recenzii preluate de pe 0 canal(e)
Canale de recenzii:
Produse asemănătoare
Categorii asemănătoare
În cazul în care Staphylococcus: Genetics and Physiology, Greg a. Somerville (Editor) nu corespunde așteptărilor tale, te invit să explorezi categoriile similare de mai jos pentru a identifica produsul potrivit:

